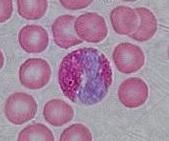
嗜酸性粒細胞

概述
嗜酸性粒細胞
嗜酸性粒細胞嗜酸性粒細胞增多綜合徵為Hardy和Ankerson(1965年)提出的一組病因不明、血及骨髓嗜酸性粒細胞持續增多、組織中嗜酸性粒細胞浸潤為特徵的一類疾病,包括Loffler綜合徵、嗜酸性粒細胞肉芽腫、Loffler心內膜炎、播散性嗜酸細胞膠原病和嗜酸性細胞白血病等。
嗜酸性粒細胞增多綜合徵,皮疹呈多形性損害,包括水腫性或浸潤性紅斑、丘疹、結節、水皰等,也可引起紅皮病,劇癢。外周血EC增多,1.5×109 /L以上,持續6個月以上。骨髓中嗜酸性粒細胞增多。具有多系統受嗜酸性粒細胞浸潤之症狀和體徵(心臟、肺、神經系統、肝、脾、腎、胃)等。
排除EC增多病因明確的有關疾病如寄生蟲病、過敏性疾患、皮膚病(皰疹樣皮炎、其它紅皮病)、血液病(淋巴瘤、紅血病)、結締組織病。
到2012年為止,全世界有記錄的,有33名兒童患者,根據美國的統計數據,這種病的發病率為1000萬分之3.6,約278萬人中才有一例,一般發病年齡在50歲左右。
病因
可能為一種超敏和自身免疫反應,在免疫反應中,肥大細胞、嗜鹼性粒細胞中性粒細胞均能釋放嗜酸性粒細胞趨化因子,補體碎片以及遲髮型變態反應中淋巴細胞所產生的某些因子都能使嗜酸性粒細胞向組織中遊走聚集,對抗原抗體複合物起吞噬作用,其發病機理與I、Ⅲ、Ⅳ型變態反應有關。
亞型
嗜酸性粒細胞增多綜合徵分為2個亞型:骨髓增殖型和淋巴細胞型。
骨髓增殖型的特點是有染色體異常,酪氨酸激酶活性增加,骨髓中異常的肥大細胞增多,循環中的肥大細胞產物(血清類胰蛋白酶)和VitB增多,以及脾大。酪氨酸激酶活性增加是因為編碼該激酶的基因發生了重排。
骨髓增殖型HES多發於男性,而淋巴細胞型的男女發病比例相當。淋巴細胞型以皮膚表現為主,主要表現有濕疹、瘙癢症、紅皮病、蕁麻疹和血管性水腫等,很少發展為心肌纖維化。該型病人有獨特表型的T細胞克隆,通常為CD3- CD4+ ,多克隆免疫球蛋白特別是IgE升高。此亞型最後可發展為淋巴瘤。
體徵
全身症狀可有發熱、疲倦、體重下降、浮腫、關節腫痛、肌肉疼痛、肌無力等。
本病以男性中年多見,有皮疹者占27%—53%。皮疹一般分兩類:①蕁麻疹和血管性水腫;②紅斑、丘疹和結節,包括水腫性紅斑、瀰漫性浸潤性紅斑、多形紅斑、麻疹樣紅斑、紅皮病等。此外有蕁麻疹樣、痒疹樣、膿皮病樣及黃色瘤樣皮疹,亦有水皰、潰瘍、瘀點、色素沉著斑、角化過度等。
皮疹消退後多不留痕跡,亦可有色素沉著和瘢痕。可以僅有一種疹型,或兩種或多種疹型並存。皮疹分布呈全身性,無好發部位,可分布於頭面、軀幹和四肢,或僅限於肢體一部分。自覺瘙癢或劇癢。皮疹持續,或緩解後復發。
心血管系統可有心肌病變,充血性心力衰竭,此外有心臟擴大、心律失常、高血壓、心電圖及超聲心動圖異常等。
呼吸系統有咳嗽、胸痛、呼吸困難、哮喘,可聞及乾濕噦音、哮鳴音,亦有胸腔積液及胸部X片有浸潤陰影等。
神經系統有昏迷、精神錯亂等,也有視力模糊、言語不清、運動失調和周圍神經炎等。
此外,可有腹痛、腹瀉、肝脾腫大、全身淺表淋巴結腫大等。
病程及預後:除嗜酸細胞性白血病外,多數患者呈慢性進行性經過。死亡原因主要為嗜酸性粒細胞增多性心肌病和心臟擴大引起的心力衰竭,此外為肝腎功能障礙。
流行病學
HES成人罕見,兒童極罕見。HES的發病年齡不定,可在從幼兒至老年人的任一階段發生,但大部分病人(70%)的發病年齡介於20—50歲之間。歐洲和北美報告的大部分患者(大約三分之二)是高加索人,男性比女性更易患,男/女之比為4∶1至9∶1。
診斷
診斷依據:
①外周血持續性嗜酸性粒細胞增多,絕對計數超過1500×106 /L達6個月以上。
②骨髓中嗜酸性粒細胞增多。
③除外嗜酸性粒細胞增多的其它疾病,如寄生蟲病、過敏性疾病等。
④有皮膚等組織和臟器受累證據。
實驗室檢查:有貧血,大多數患者末梢血白細胞增多,總數為(10—30)×109 /L,嗜酸性粒細胞增多達0.3—0.7(30%—70%),甚至達0.9(90%)。骨髓象示顆粒細胞增生,主要為嗜酸性粒細胞。血清IgE增高,IgG、IgA、IgM、γ-球蛋白、CIC、補體亦可增高,類風濕因子和C反應蛋白可陽性。
治療
治療的原則是通過降低外周血EC數從而控制症狀及減輕器官損害。
皮質類固醇和免疫抑制劑(環磷醯胺等)治療可獲暫時臨床緩解。因藥物療效不肯定,且有嚴重副作用,故有主張在出現進行性臟器受損和功能障礙時為使用指征。雷公藤和其他中醫藥療法亦有效,或小劑量皮質類固醇與雷公藤合用。曾報告套用肥大細胞穩定劑色甘酸鈉200mg,1日4次飯前服,取得滿意療效。
案例
 靚靚
靚靚2012年7月下旬,9歲女孩靚靚被轉入南方醫科大學南方醫院治療,10天后,被確診為一種極為罕見的基因疾病——嗜酸性粒細胞增多綜合徵。
到2012年11月21日,靚靚病情逐漸好轉。醫生表示,發病原因可能與母親在懷孕時接觸化學物品有關。
靚靚出生一個月後,全身出現紅色斑點,大小不一的丘疹、丘皰疹、水泡和滲液,瘙癢嚴重。6歲時右眼失明,左眼弱視。8歲時突發“腦中風”,心、腦、肺、肝、腎等重要臟器逐漸受累並加重,皮膚瘙癢更為劇烈,全身潰爛,甚至被多家醫院拒絕收治。

